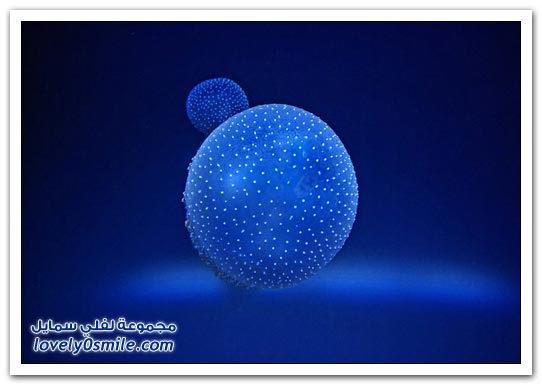

رسومات تحاكي الحقيقة
تاريخ الإضافة :

شاهد أيضا :
مواضيع ذات صلة
إضف تعليقك
تعليقات الزوار (1)
ملاحظة للأخوة الزوار : التعليقات لا تعبر بالضرورة عن رأي موقع لفلي سمايل أو منتسبيه، إنما تعبر عن رأي الزائر وبهذا نخلي أي مسؤولية عن الموقع..

saadhusen
رسومات جيده لفنان مميز وفعلأ رسومات تحاكي الحقيقه الاصليه